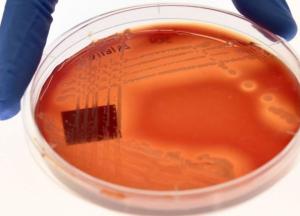

Правительство Великобритании: К 2050 году супербактерии будут убивать около 10 миллионов человек в год
Глобальная смертность, вызванная супербактериями будет больше, чем от рака и сахарного диабета вместе взятых. Правительство Великобритании предупреждает: «Достижения современной медицины будут потеряны»
Политические деятели заявили, что растущее количество вирусов, паразитов и бактерий, становящихся устойчивыми к антибиотикам, представляет собой «серьезную опасность для здоровья». Если министры ничего не предпримут, то «наработки современной медицины будут утеряны», добавили они.
Серьезность положения доказывает отчет комитета по сбору средств на здравоохранение и социальную помощь, который тщательно изучает работу правительства в этих областях.
В Великобритании уже наблюдается рост устойчивых к антибиотикам заболеваний, которые убивают в этой стране около 5000 человек в год. Эксперты утверждают, что число погибших может достигнуть 10 миллионов в год в мировом масштабе в течение следующих 30 лет.
Всему виной фармацевтические компании, не имеющие достаточного финансового стимула для открытия новых классов антибиотиков, и занимающиеся бесполезными исследованиями в течение десятилетий.
Политики предложили сократить количество «несоответствующих» рецептов, изменить патентное право и увеличить выплаты фармацевтическим компаниям за новые антибиотики.
Страхи усиливаются и из-за новых пищевых стандартов после Брексита, поскольку антибиотики, используемые в сельском хозяйстве, являются «важным фактором» сопротивления человеческого организма новым вирусам и бактериям.
Комитет потребовал, чтобы любые торговые сделки, совершенные после того, как Великобритания покинет ЕС, должны гарантировать, что импортированная мясная молочная продукция соответствует тем же стандартам по антибиотикам, что и в ЕС.
Министры признали, что супербактерии требуют «скоординированных международных действий».
Напомним, что в мае правительство Великобритании пообещало выделить 30 миллионов фунтов стерлингов на борьбу с глобальным бедствием устойчивости к антибиотикам.

На перетині галузей: чому Defense Tech в Україні перетворюється на глобальну індустрію подвійних технологій
Тріщини у моноліті: у РФ зафіксували рекордний сплеск недовольства, а регіони відкрито зловтішаються з обстрілів Москви
Зміна світового порядку: як Сі Цзіньпін переграв Трампа на саміті в Пекіні
Економічний глухий кут РФ: чому Путін знову летить до Китаю і повернеться ні з чим
Як київський X-Park виживає під час війни: обрубані крила авіації, прильоти та реабілітація ветеранів на пузі
Плівки Міндіча: як Банкова та СБУ намагалися врятувати «бек-офіс» від розслідувань НАБУ
Крах російської економіки в глибинці: чому офіційна статистика Росстату є фікцією
Анігіляція «Ахмату» на Сумщині: ГУР розкрило деталі унікальної спецоперації за участю агента-перебіжчика





